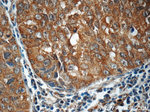
PI3K p110(alpha) Antibody in Immunohistochemistry (Paraffin) (IHC (P))

Search
Proteintech
PI3K p110(alpha) Polyclonal Antibody
{{$productOrderCtrl.translations['antibody.pdp.commerceCard.promotion.promotions']}}
{{$productOrderCtrl.translations['antibody.pdp.commerceCard.promotion.viewpromo']}}
{{$productOrderCtrl.translations['antibody.pdp.commerceCard.promotion.promocode']}}: {{promo.promoCode}} {{promo.promoTitle}} {{promo.promoDescription}}. {{$productOrderCtrl.translations['antibody.pdp.commerceCard.promotion.learnmore']}}
产品信息
21890-1-AP
宿主/亚型
分类
类型
抗原
偶联物
形式
浓度
规格
保存条件
运输条件
产品详细信息
The antibody is specific to PIK3CA.
靶标信息
Phosphatidylinositol 3-kinase is composed of an 85 kDa regulatory subunit and a 110 kDa catalytic subunit. The protein encoded by this gene represents the catalytic subunit, which uses ATP to phosphorylate PtdIns, PtdIns4P and PtdIns(4,5)P2. This gene has been found to be oncogenic and has been implicated in cervical cancers.
仅用于科研。不用于诊断过程。未经明确授权不得转售。